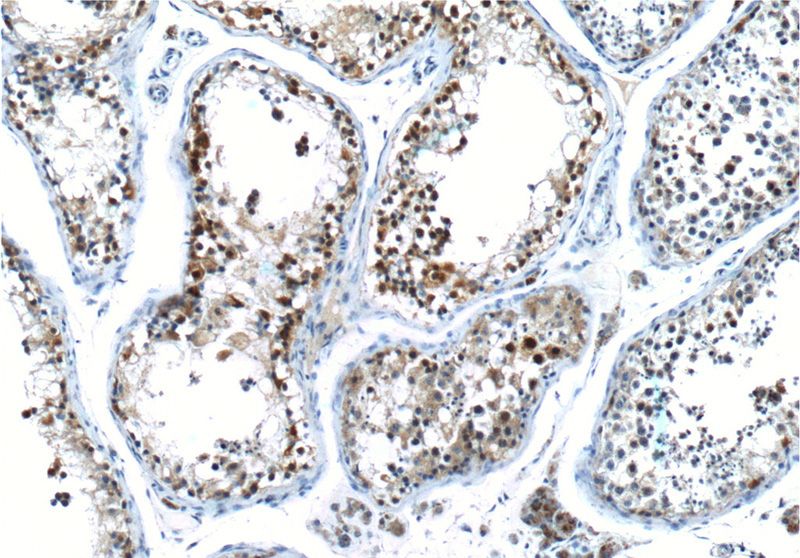
Immunohistochemistry of paraffin-embedded human testis tissue slide using Catalog No:109666(CCNE2 Antibody) at dilution of 1:50 (under 10x lens).

-
Product Name
Cyclin E2 antibody
- Documents
-
Description
Cyclin E2 Rabbit Polyclonal antibody. Positive FC detected in HeLa cells. Positive IF detected in HeLa cells. Positive IHC detected in human testis tissue, human breast cancer tissue. Positive WB detected in Jurkat cells. Observed molecular weight by Western-blot: 44 kDa
-
Tested applications
ELISA, WB, IF, FC, IHC
-
Species reactivity
Human; other species not tested.
-
Alternative names
CCNE2 antibody; CYCE2 antibody; cyclin E2 antibody; G1/S specific cyclin E2 antibody
-
Isotype
Rabbit IgG
-
Preparation
This antibody was obtained by immunization of Cyclin E2 recombinant protein (Accession Number: BC020729). Purification method: Antigen affinity purified.
-
Clonality
Polyclonal
-
Formulation
PBS with 0.1% sodium azide and 50% glycerol pH 7.3.
-
Storage instructions
Store at -20℃. DO NOT ALIQUOT
-
Applications
Recommended Dilution:
WB: 1:500-1:5000
IHC: 1:20-1:200
IF: 1:20-1:200
-
Validations

Jurkat cells were subjected to SDS PAGE followed by western blot with Catalog No:109666(CCNE2 antibody) at dilution of 1:800

Immunofluorescent analysis of HeLa cells using Catalog No:109666(CCNE2 Antibody) at dilution of 1:50 and Rhodamine-Goat anti-Rabbit IgG
Immunohistochemistry of paraffin-embedded human testis tissue slide using Catalog No:109666(CCNE2 Antibody) at dilution of 1:50 (under 10x lens).

Immunohistochemistry of paraffin-embedded human testis tissue slide using Catalog No:109666(CCNE2 Antibody) at dilution of 1:50 (under 40x lens).

1X10^6 HeLa cells were stained with 0.2ug CCNE2 antibody (Catalog No:109666, red) and control antibody (blue). Fixed with 90% MeOH blocked with 3% BSA (30 min). Alexa Fluor 488-congugated AffiniPure Goat Anti-Rabbit IgG(H+L) with dilution 1:1500.
-
Background
Cyclin E2 (CCNE2) belongs to the highly conserved cyclin family, whose members are characterized by a dramatic periodicity in protein abundance throughout the cell cycle. Cyclins function as regulators of cyclindependent kinases (CDKs). Different cyclins exhibit distinct expression and degradation patterns which contribute to the temporal coordination of cell cycle events. CCNE2 forms a complex with and functions as a regulatory subunit of CDK2 and has been shown to specifically interact with CIP/KIP family of CDK inhibitors. CCNE2 plays a role in cell cycle G1/S transition and its expression peaks at the G1-S phase. Whereas cyclin E1 is expressed in most proliferating normal and tumor cells, cyclin E2 levels are low or undetectable in nontransformed cells, and are elevated in tumor-derived cells.
-
References
- Gong K, Xie J, Yi H, Li W. CS055 (Chidamide/HBI-8000), a novel histone deacetylase inhibitor, induces G1 arrest, ROS-dependent apoptosis and differentiation in human leukaemia cells. The Biochemical journal. 443(3):735-46. 2012.
- Hu HM, Chen Y, Liu L. C1orf61 acts as a tumor activator in human hepatocellular carcinoma and is associated with tumorigenesis and metastasis. FASEB journal : official publication of the Federation of American Societies for Experimental Biology. 27(1):163-73. 2013.
- Song Y, Gong K, Yan H. Sj7170, a unique dual-function peptide with a specific α-chymotrypsin inhibitory activity and a potent tumor-activating effect from scorpion venom. The Journal of biological chemistry. 289(17):11667-80. 2014.
- Xiao W, Jiang Y, Men Q. Tetrandrine induces G1/S cell cycle arrest through the ROS/Akt pathway in EOMA cells and inhibits angiogenesis in vivo. International journal of oncology. 46(1):360-8. 2015.
Related Products / Services
Please note: All products are "FOR RESEARCH USE ONLY AND ARE NOT INTENDED FOR DIAGNOSTIC OR THERAPEUTIC USE"
